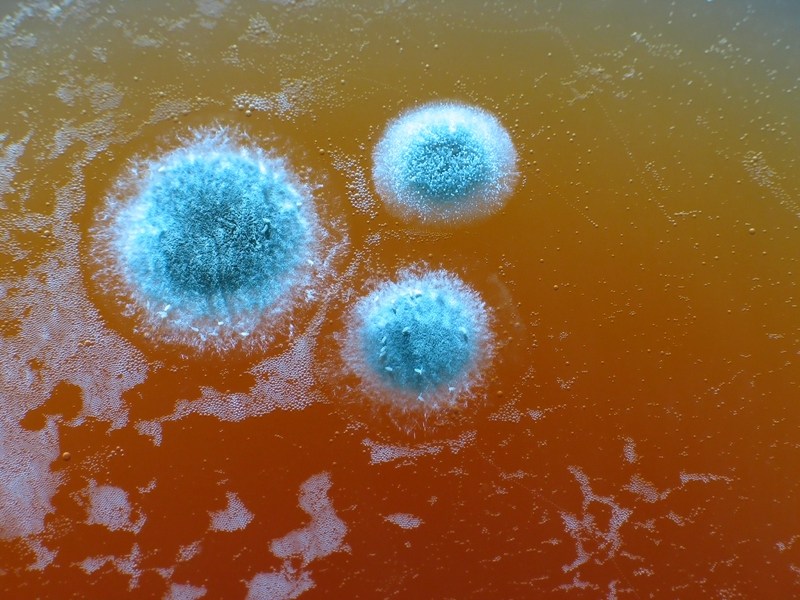

Dunn Environmental Services, Inc.
About us
DUNN ENVIRONMENTAL SERVICES Inc. provides high quality, cost effective, environmental consulting, and industrial hygiene services throughout the U.S. Our pricing has been reduced to help aid residential and commercial clients. Services has included a client login so our customers can retrieve access to all aspects of their findings, reports and photos when needed. To review your reports online, contact us to receive your username and password. All employees are certified in all aspects of the field.
Business highlights
Services we offer
Asbestos sampling, mold sampling, lead sampling, Indoor Air Quality sampling, OSHA compliance sampling, soot sampling
Services we don't offer
Remediation, Home inspections, Cleaning, Lead removal.
Amenities
Emergency Services
Yes
Accepted Payment Methods
- Check
- Visa
- MasterCard
- 3
Assorted photos uploaded by Dunn Environmental Services, Inc.
Licensing
State Contractor License Requirements
All statements concerning insurance, licenses, and bonds are informational only, and are self-reported. Since insurance, licenses and bonds can expire and can be cancelled, homeowners should always check such information for themselves. To find more licensing information for your state, visit our Find Licensing Requirements page.
*Contact business to see additional licenses.